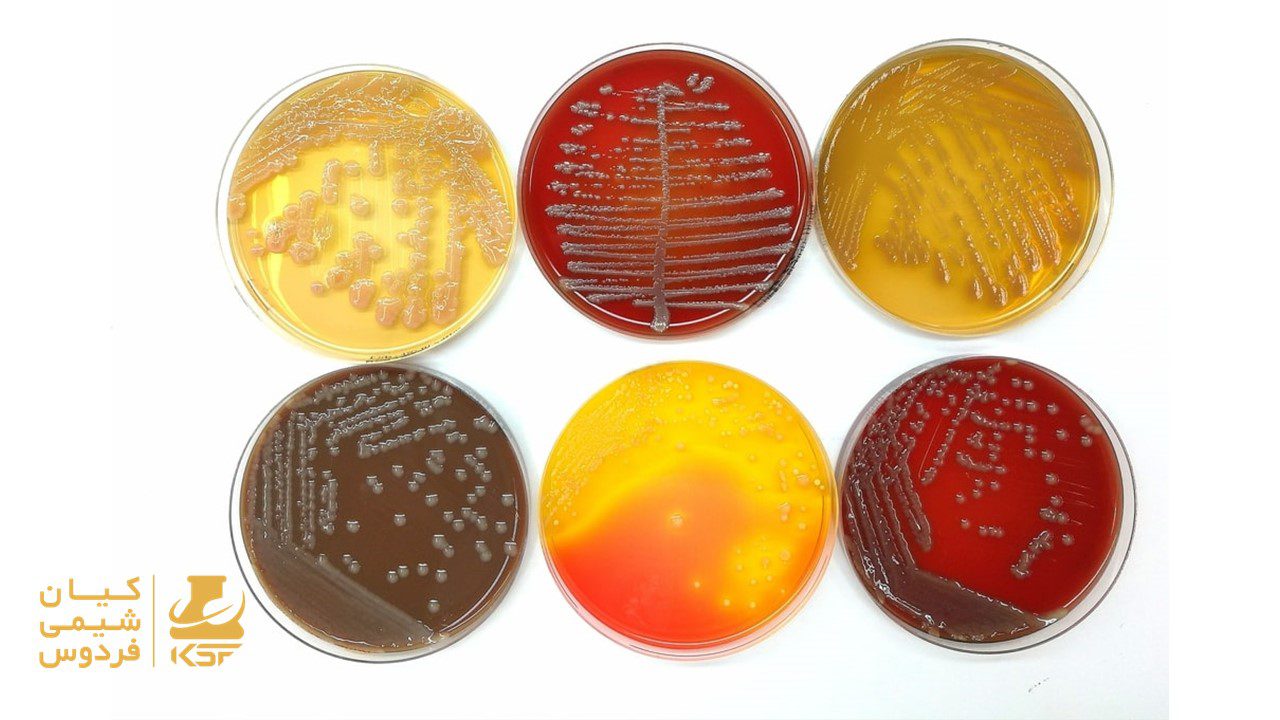
محیط کشت چیست؟

محیط کشت چیست؟
معرفی محیط کشت و انواع آن
محیط کشت به مخلوطی از مواد غذایی و شیمیایی گفته میشود که برای رشد و پرورش میکروارگانیسمها، گیاهان، یا سلولها در آزمایشگاهها یا مراکز تحقیقاتی طراحی شده است. این محیطها میتوانند بهطور خاص برای نیازهای جانداران مختلف تنظیم شوند تا بهترین شرایط رشد و توسعه را فراهم کنند.
اجزای اصلی تشکیل دهنده محیط کشت چیست؟
اجزای اصلی محیط کشت به صورت زیر تقسیمبندی میشود:
منابع غذایی
- کربوهیدراتها: مانند گلوکز یا ساکارز که انرژی لازم را برای رشد میکروارگانیسمها و سلولها فراهم میکنند.
- پروتئینها: شامل پپتونها (که از هیدرولیز پروتئینهای حیوانی بهدست میآیند) که اسیدهای آمینه مورد نیاز برای ساخت پروتئینهای سلولی را تأمین میکنند.
- ویتامینها: مواد مغذی ضروری برای متابولیسم و رشد میکروارگانیسمها و سلولها.
عناصر معدنی
- شامل نمکها و مواد معدنی که برای فعل و انفعالات بیوشیمیایی و حفظ عملکرد سلولی ضروریاند، از جمله:
- نیتروژن: برای ساخت آمینواسیدها و پروتئینها.
- فسفر: در ساخت DNA و RNA و به عنوان منبع انرژی در ATP.
- پتاسیم، کلسیم و منیزیم: برای متابولیسم سلولی و حفظ تعادل الکترولیتی.
آب
- حلال اصلی: آب به عنوان یک حلال، تمامی مواد مغذی را حل کرده و میکروارگانیسمها یا سلولها را در خود معلق میکند. همچنین، آب برای حفظ حیات و فعالیتهای متابولیکی ضروری است.
محیط پشتیبان (آگار)
- آگار: یک پلیساکارید است که از جلبکهای دریایی استخراج میشود و بهعنوان یک ماده جامدکننده در محیطهای کشت جامد یا نیمهجامد استفاده میشود. آگار ساختار محیط را حفظ میکند و به میکروارگانیسمها اجازه میدهد تا بهراحتی رشد کنند.
pH
- تنظیم pH: سطح pH محیط کشت برای رشد میکروارگانیسمها و سلولها بسیار مهم است. pH ایدهآل به نوع میکروارگانیسم یا سلول بستگی دارد، و تنظیم مناسب آن به حفظ فعالیتهای متابولیکی کمک میکند.
عوامل دیگر
- الماس انرژی (ATP): در برخی محیطها بهمنظور حمایت از فعالیتهای متابولیکی، ممکن است مواد اضافی مانند ATP به محیط اضافه شود.
- محیطهای ضدعفونیکننده (Antibiotics): در برخی محیطها برای جلوگیری از آلودگی، مواد ضدعفونیکننده اضافه میشود.
- فاکتورهای رشد: در محیطهای کشت سلولهای جانوری، ممکن است فاکتورهای رشد ویژهای بهمنظور بهبود تکثیر و زندهمانی سلولها اضافه شوند.
اهمیت محیط کشت در زندگی میکروارگانیسمها
میکروارگانیسمها برای زنده ماندن و تکثیر به محیطی نیاز دارند که دارای مواد غذایی، دما، فشار اسمزی و دیگر شرایط مناسب باشد. محیطکشت مصنوعی بهعنوان جایگزینی برای محیطهای زیست طبیعی این نیازها را برآورده میکند.
انواع محیط کشت بر اساس حالت فیزیکی
محیطکشتها براساس حالت فیزیکی به سه دسته تقسیم میشوند:
- محیط کشت جامد: این محیطها معمولاً شامل آگار هستند و به میکروارگانیسمها اجازه میدهند تا در یک محیط ثابت رشد کنند. نمونههایی از این نوع محیطها عبارتند از:
- نوتری گنت آگار
- پپرونیک آگار
- محیط کشت نیمهجامد: این محیطها دارای غلظت کمتری از آگار هستند و برای کشت میکروارگانیسمها در محیطهایی با خاصیت حرکتی مثل باکتریهای متحرک استفاده میشوند.
- محیط کشت مایع: این نوع محیطها بدون آگار هستند و معمولاً برای کشتهای بزرگتر استفاده میشوند. نمونههایی از آنها شامل محیطهای کشت مایع مثل “TSB” (Trypticase Soy Broth) هستند.
انواع محیط کشت بر اساس نوع کاربرد
محیطکشتها همچنین میتوانند بر اساس ویژگیهای کاربردی به چهار دسته تقسیم شوند:
- محیط کشت عمومی (ساده): این محیطها برای طیف وسیعی از میکروارگانیسمها مناسب هستند و برای کشت عمومی استفاده میشوند. مثلاً نوتری گنت آگار.
- محیط کشت غنیشده: این محیطها دارای غلظت بیشتری از مواد مغذی هستند و برای رشد میکروارگانیسمهای خاص و سختگذر طراحی شدهاند. بهعنوان مثال، محیطهای عصاره گوشت.
- محیط کشت افتراقی: این نوع محیطها بهمنظور تشخیص و شناسایی تفاوتهای بین میکروارگانیسمها طراحی شدهاند. به طور مثال، محیط کشت “ماک کانکی آگار” که برای تشخیص باکتریهای گرم منفی به کار میرود.
- محیط کشت اختصاصی (انتخابی): این محیطها به گونههای خاصی از میکروارگانیسمها اجازه میدهند که رشد کنند و بهطور خاص دیگر گونهها را مهار میکنند. مثلاً “منیتول سالت آگار” که بهمنظور جداسازی استافیلوسوکوکوس استفاده میشود.
شرایط محیط
برای رشد بهینه میکروارگانیسمها، برخی از شرایط زیر نیز باید رعایت شود:
- دمای مناسب: اکثر میکروارگانیسمها در دماهای خاصی رشد میکنند. برای مثال، باکتریهای گرمادوست در دماهای 37 درجه سانتیگراد بهترین رشد را دارند.
- فشار اسمزی: باید بتواند تنظیم نامتعادل اسمزی را ایجاد کند که به سلولها آسیب نرساند.
محیط کشت جامد (Solid)
این محیطها دارای پسوند “آگار” هستند و با افزودن ۲ تا ۳ درصد آگار به مایع، حالت جامد به خود میگیرند.
- ویژگیها:
- آگار مادهای طبیعی و گیاهی است که بعد از جوشیدن و حل شدن در آب، در دمای زیر ۴۵ درجه سانتیگراد به حالت جامد درمیآید.
- آگار به تنهایی مقادیر کافی مواد مغذی ندارد و معمولاً با دیگر مواد مغذی مخلوط میشود.
- مثال:
- نوترینت آگار (Nutrient Agar): یک محیط عمومی برای رشد انواع مختلف باکتریها.
محیط کشت مایع (Fluid)
این نوع محیطکشتها دارای پسوند “براث” (Broth) هستند و به صورت مایع وجود دارند.
- ویژگیها:
- این محیطها حالت جامد ندارند و معمولاً برای کشت مقادیر زیاد باکتریها و تجزیه و تحلیل متابولیسم آنها استفاده میشوند.
- مثال:
- نوترینت براث (Nutrient Broth): برای کشت میکروارگانیسمها در شرایط مایع.
محیط کشت نیمه جامد (Semisolid)
این نوع محیطکشتها بهوسیله افزودن ۱ تا ۱.۵ درصد آگار به محیط مایع تولید میشوند و معمولاً برای بررسی حرکت باکتریها و آزمایشهای حرکتی استفاده میشوند.
- ویژگیها:
- اجازه میدهند باکتریهای متحرک بهراحتی در آن حرکت کنند و رشد کنند.
انواع محیط کشت بر اساس متمایزسازی
محیطکشتها همچنین میتوانند بر اساس ویژگیهای خاص و تواناییهای تمایزدهی تقسیمبندی شوند:
- محیطکشتهای عمومی (ساده):
- این محیطها شامل کلیه مواد لازم برای رشد میکروارگانیسمها هستند و بهعلت نداشتن مواد ضد میکروبی، تقریباً تمامی باکتریها میتوانند در آن رشد کنند.
- مثال: نوتری گنت آگار.
- محیطکشتهای غنیشده:
- با اضافه کردن خون یا سرم به محیطهای ساده، برای حمایت از رشد باکتریهای پرنیاز طراحی شدهاند.
- مثال: بلاد آگار (Blood Agar).
- محیطکشتهای افتراقی:
- این محیطها با داشتن مواد شیمیایی خاص، برخی از باکتریها را از یکدیگر متمایز میکنند.
- مثال: ماککانکی آگار (MacConkey Agar) که بهواسطه تخمیر لاکتوز میتواند باکتریهای لگنومونی یا انترو باکتریاسه را شناسایی کند.
- محیطکشتهای اختصاصی (انتخابی):
- این محیطها تنها برای رشد نوع خاصی از باکتریها طراحی شدهاند و بهگونهای تنظیم شدهاند که از رشد دیگر باکتریها جلوگیری کنند.
- مثال: منیتول سالت آگار (Mannitol Salt Agar)، که بهمنظور جداسازی استافیلوکوکها (به ویژه استافیلوکوکوس اورئوس) طراحی شده است.
اصول تهیه محیط کشت
- استفاده از پودرهای آماده
- بیشتر محیطهای کشت بهصورت پودرهای آماده در دسترس هستند. برای تهیه هر محیط، حجم مشخصی از پودر باید با مقدار مناسبی آب مقطر مخلوط شود.
- مخلوط کردن پودر با آب
- مقدار لازم از پودر را در ارلن مایر ریخته و به تدریج آب مقطر را اضافه کنید. مهم است که مخلوط به خوبی هم زده شود تا جلوگیری از گلوله شدن آن شود.
- حل کردن آگار
- در صورتی که محیط کشت دارای آگار باشد، پس از مخلوط کردن پودر و آب، باید مخلوط برای یک دقیقه جوشانده شود تا رنگ محیط کاملاً شفاف شود.
- برای این کار میتوانید از بن ماری یا شعله مستقیم استفاده کرده و بین آنها مداوم هم بزنید تا آگار ته نگیرد و نسوزد.
- استرلیزاسیون
- پس از آماده شدن محیط، باید آن را بهوسیله اتوکلاو استریل کرد. در برخی محیطهای اختصاصی مانند سالمونلا شیگلا آگار، استرلیزاسیون ضروری نیست.
- خالی کردن محیط در پلیت یا لوله آزمایش
- اگر میخواهید محیط را در پلیت تهیه کنید، پس از استرلیزاسیون، اجازه دهید دما به حدود ۴۵ تا ۵۰ درجه سانتیگراد کاهش یابد و سپس ۱۰ تا ۱۵ سیسی در هر پلیت بریزید.
- برای حذف حبابهای هوای موجود، سطح محیط در هر پلیت را با شعله شعلهدهی کنید.
- تهیه محیط کشت در لوله آزمایش
- پس از مخلوط کردن و حرارت دادن، محیط را در لولههای آزمایش تقسیم کرده و آنها را استریل کنید. معمولاً لولهها را تا یکسوم پر میکنند و سپس به دقت مسدود میشوند.
- نگهداری و بررسی آلوده بودن
- محیطهای پلیتی و لولهای باید به مدت ۲۴ ساعت در انکوباتور بهصورت وارونه قرار گیرند تا از آلوده بودن آنها اطمینان حاصل شود.
- تا زمان مصرف، محیطها باید بهصورت وارونه در یخچال نگهداری شوند تا از تبخیر آب جلوگیری شود. در شرایط مناسب، این محیطها را میتوان تا یک هفته استفاده کرد.
نکات مهم هنگام استفده از محیط کشت
در هنگام استفاده از محیطهای کشت، رعایت نکات مهمی میتواند تأثیر زیادی بر دقت و کیفیت نتایج آزمایشات میکروبی داشته باشد. در ادامه، به چند نکته کلیدی اشاره میشود:
- استرلیزاسیون صحیح:
- اطمینان حاصل کنید که محیط کشت بهطور کامل استریل شده باشد. هر گونه آلودهگی میتواند بر نتایج آزمایش تأثیر منفی بگذارد.
- حفظ شرایط استریل:
- در تمام مراحل کار با محیط کشت، از جمله هنگام باز کردن میل لاستیکی محیط، استفاده از شعله مستقیم و همچنین هنگام انتقال نمونهها، از شرایط استریل استفاده کنید.
- انکوباسیون در دما و زمان مناسب:
- محیطهای کشت باید در دمای مناسب (بسته به نوع باکتری) و برای زمان مشخصی انکوبه شوند. دقت در زمان و دما میتواند بر روی نتایج تأثیر بگذارد.
- استفاده از تکنیکهای درست:
- از تکنیکهای صحیح کشت و انتقال نمونه استفاده کنید. مثلاً هنگام استفاده از پلیتها، از لوپ استریل برای انتقال باکتریها استفاده کنید.
- رعایت طرز نگهداری:
- محیطهای کشت را در دمای مناسب و بهصورت وارونه در یخچال نگهداری کنید تا از تبخیر آب و آلودگی جلوگیری شود.
- چک کردن از نظر آلودگی:
- پس از انکوباسیون، محیط کشت را از نظر آلودگی بررسی کنید. وجود هر گونه تغییر رنگ، شکل یا بافت غیرعادی میتواند نشانه آلودگی باشد.
- ثبت نتایج و مشاهدات:
- بهطور منظم و دقیق مشاهدات خود را ثبت کنید. این اطلاعات برای تحلیل و ارزیابی نتایج آزمایشات بسیار مفید است.
- رعایت تاریخ انقضا:
- از استفاده از محیطهای کشت با تاریخ انقضا گذشته خودداری کنید و به تاریخ انقضا و شرایط نگهداری آنها توجه کنید.
- آمادهسازی مجدد:
- در صورت مشاهده هیچ رشد یا رشد غیرعادی، ممکن است نیاز به تهیه مجدد محیط کشت داشته باشید.
- آموزش کار با محیطکشت:
- اطمینان حاصل کنید که افرادی که با محیطهای کشت کار میکنند، آموزشهای لازم را دیدهاند و با تکنیکهای کاری آشنا هستند.
جمعبندی
محیطهای کشت یکی از ارکان اصلی تحقیقات میکروبی هستند که برای رشد، جداسازی و شناسایی میکروارگانیسمها به کار میروند. این محیطها به دستههای مختلفی تقسیم میشوند و هر یک ویژگیها و کاربردهای خاص خود را دارند. در اینجا به جمعبندی نکات کلیدی درباره محیط کشت میپردازیم:
- انواع محیط کشت:
- محیطهای ساده: تشکیلدهنده پایه برای رشد تمام میکروبها.
- محیطهای غنیشده: حاوی مواد مغذی اضافی برای باکتریهای خاص.
- محیطهای افتراقی: توانایی شناسایی تفاوتهای میان باکتریها از طریق ویژگیهای خاص.
- محیطهای انتخابی: ممانعت از رشد برخی از باکتریها به نفع باکتریهای خاص.
- محیطهای اختصاصی: طراحی شده برای رشد نوع خاصی از میکروارگانیسمها.
- محیطهای مایع: مناسب برای کشتهای بزرگ و صنعتی.
- اهمیت تهیه و استفاده صحیح:
- رعایت اصول تهیه و استرلیزاسیون محیط کشت برای جلوگیری از آلودگی و اطمینان از نتایج معتبر بسیار حیاتی است.
- حفظ شرایط مناسب نگهداری و استفاده از تکنیکهای استریل در همه مراحل کار با محیط کشت.
- کاربردها:
- محیطهای کشت بهطور گسترده در تحقیقات میکروبی، تشخیص بالینی، تولید واکسن و بررسی عوامل بیماریزا استفاده میشوند.
- همچنین، در صنایع غذایی و دارویی برای کنترل کیفیت و ایمنی محصولات به کار میروند.
- نگهداری و بررسی:
- پس از انکوباسیون، بررسی محیطهای کشت از نظر آلودگی و ثبت نتایج برای تحلیل دقیق و معتبر ضروری است.
- محیطهای کشت باید بهطور مناسب نگهداری و در صورت عدم استفاده بهموقع از بین بروند.
محیطهای کشت ابزارهای ضروری در میکروبیولوژی هستند که درک صحیح و استفاده بهینه از آنها میتواند بهطور قابل توجهی نتایج تحقیقات و تحلیلهای میکروبی را بهبود بخشد. با انتخاب مناسب محیط کشت و رعایت اصول کار با آن، میتوان به دقت و کیفیت مطلوبی در تحقیقات میکروبی دست یافت.